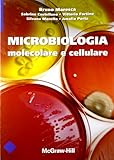

Cercando Microbiologia molecolare e cellulare. Ediz. illustrata?
Microbiologia molecolare e cellulare. Ediz. illustrata l'e-book può essere scaricato gratuitamente. Get e-book gratuiti Microbiologia molecolare e cellulare. Ediz. illustrata. Scarica gratuitamente eBook Microbiologia molecolare e cellulare. Ediz. illustrata. Scarica ora e-book Microbiologia molecolare e cellulare. Ediz. illustrata.

Microbiologia molecolare e cellulare. Ediz. illustrata l'e-book può essere scaricato gratuitamente. Get e-book gratuiti Microbiologia molecolare e cellulare. Ediz. illustrata. Scarica gratuitamente eBook Microbiologia molecolare e cellulare. Ediz. illustrata. Scarica ora e-book Microbiologia molecolare e cellulare. Ediz. illustrata.
Author:
Publication Date:
Number Of Pages:
Rating: 4.0
Total Reviews: 2
Publication Date:
Number Of Pages:
Rating: 4.0
Total Reviews: 2


0 komentar:
Posting Komentar
Catatan: Hanya anggota dari blog ini yang dapat mengirim komentar.